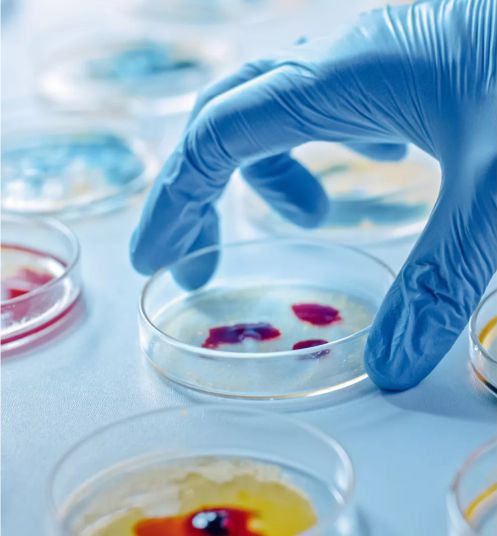

- Ultra-Fast Scans: Complete full-body scans in seconds, reducing wait time and discomfort.
- High-Resolution Imaging: Clearer, sharper images for more accurate diagnosis.
- Low Radiation Dose: Advanced technology ensures maximum safety with minimal exposure.
- Detects Even Tiny Issues: Ideal for early detection of heart disease, cancer, and stroke.
- Comfortable & Quick Experience: Smooth, non-invasive scans with minimal prep time.
- Same-Day Reports: Fast diagnosis means faster treatment decisions.
- Trusted by Top Doctors: Preferred by leading specialists for precision and reliability.